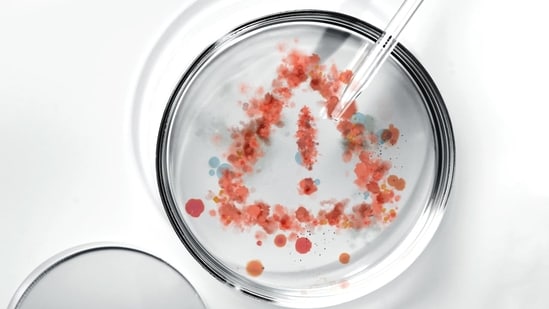
The source of the trouble is “paper mills,” businesses or individuals that charge fees to publish fake studies in legitimate journals under the names of desperate scientists whose careers depend on their publishing record. The rate of fake papers generated by these operators roughly doubled every 1.5 years between 2016 and 2020, according to href=

Akshay Kumar downplays romancing Wamiqa Gabbi, 32, in Bhooth Bangla, Priyadarshan says 'actor's screen age is different'Apart from Akshay Kumar, Bhoot Bangla director Priyadarshan also addressed the age-gap, emphasising that he sees no issue with it. Mar 25, 2026
CoinDCX promoters Sumit Gupta and Neeraj Khandelwal, arrested in a ₹71.6 lakh fraud case, were granted bail by a Thane court. The duo was accused of cheating an insurance advisor with false cryptocurrency investment and franchise promises. Their defense argued mistaken identity
Jewar Airport latest update: IndiGo, Akasa Air and Air India Express confirm flight operations, expected routes, and launch timeline for Noida International Airport. The upcoming Noida International Airport in Jewar is set to emerge as a major aviation hub for North India
Energy-related infrastructure in Iran’s Isfahan province and the southwestern city of Khorramshahr has been struck, according to Iran’s semiofficial Fars news agency. The reported attacks come a day after US President Donald Trump announced a pause by extending his deadline for Iran to halt
The controversy surrounding the Satara Zilla Parishad elections has intensified into a major political confrontation, with the suspension of the district’s top police officer following allegations of high-handedness. Legislative Council Deputy Chairperson Neelam Gorhe Monday ordered the
The Indian Premier League (IPL) 2026 season is set to get underway on March 28 with defending champions Royal Challengers Begaluru facing Sunrisers Hyderabad at the M Chinnaswamy Stadium in Bengaluru. With a fresh stack of players across all 10 franchise following the mini-auction process from last
A Delhi court on Tuesday sentenced Kashmiri separatist leader Asiya Andrabi to life imprisonment, PTI reported. Andrabi, alleged to be the founder and chief of the banned all-women separatist group Dukhtaraan-e-Millat, and two of her associates had been convicted under the Unlawful Activities
Dhurandhar 2: The Revenge has sparked fresh buzz after viewers realised that the character Pinda is inspired by real-life drug dealer and militant Rinda. This detail is now being widely discussed as fans connect the film’s story with real events
The source of the trouble is “paper mills,” businesses or individuals that charge fees to publish fake studies in legitimate journals under the names of desperate scientists whose careers depend on their publishing record. The rate of fake papers generated by these operators roughly doubled every 1.5 years between 2016 and 2020, according to href="https://www.pnas.org/doi/full/10.1073/pnas.2420092122">a study published Monday in the Proceedings of the National Academy of Sciences.
The source of the trouble is “paper mills,” businesses or individuals that charge fees to publish fake studies in legitimate journals under the names of desperate scientists whose careers depend on their publishing record.
The rate of fake papers generated by these operators roughly doubled every 1.5 years between 2016 and 2020, according to href="https://www.pnas.org/doi/full/10.1073/pnas.2420092122">a study published Monday in the Proceedings of the National Academy of Sciences.
“The entire structure of science could collapse if this is left unaddressed,” said study author Luís Amaral, a physicist at Northwestern University.
Paper mills look for weak links, such as lax verification protocols, in the typically rigorous publication machinery, then exploit those to place hundreds of fabricated studies with vulnerable journals or publishers, according to scientist investigators who have been tracking and cataloging their work.
It can be a costly mess to clean up.
Publishers who have become aware of suspected paper mill activity have been forced to retract hundreds of papers at once, and in some cases shut down journals.
After retracting more than 11,300 papers that appeared compromised, Wiley, a U.S.-based publisher with a portfolio of 1,600 journals, last year announced it would shutter 19 of its publications, including some that had shown signs of takeover by paper mills.
More recently, Taylor & Francis, an academic publisher that produces more than 2,700 journals, announced in July it would stop taking submissions to its journal Bioengineered while its editors investigated past papers for paper mill activity.
But tracking the scale of these organized operations across the body of scientific literature has been difficult. When paper mills are detected, they change their tactics, and few publishers disclose when they have been targeted.
“We only know about Wiley because they have been transparent about the way that they were trying to handle these issues,” said Reese Richardson, a data scientist who studies publishing at Northwestern University who is an author on the PNAS study.
The authors of the study created a database of suspected paper mill papers, over 32,700 in all, from nearly every publisher, by assembling the work of other volunteer investigators who have been cataloging groups of studies with similar patterns that appear to come from paper mills.
With a big-data approach that spans the published scientific record, the new study confirms trends that scientist investigators of shoddy papers have shown in case studies for years.
The new study “harvests data from multiple places and triangulates signals from multiple sources to provide one of the first landscape views of the problem,” said Guillaume Cabanac, a professor of computer science at the University of Toulouse in France, one of the architects of a tool that detects faulty work in papers.
Cabanac, who wasn't involved in the PNAS study, said that more scientists and publishers are aware of the problem than a few years ago, when paper mills were viewed as a fringe issue.
The growing role of AI in all business sectors makes the trend that the new paper documents especially concerning, said James Evans, a sociologist who studies science and technology at the University of Chicago, who wasn't involved with the study.
Because large language models are consuming scientific literature without discriminating between legitimate papers and fraudulent ones, paper mills “have the potential to really muddy the waters of science and scientific understanding,” Evans said.
In an analysis of articles in the journal PLOS One, the authors demonstrate how paper mills could proliferate by targeting editors at a journal. They found that between 2006 and 2023, more than 700 articles were retracted, out of nearly 277,000 published. Of more than 18,300 editors who worked on the published articles, 22 had an unusually high rate of retraction. While they handled 0.2% of published articles, they refereed 19% of retracted studies, Richardson said.
The authors declined to name the editors they identified, but said the findings suggested that each was in charge of far more problematic papers than could be explained by chance.
Renee Hoch, head of publication ethics at PLOS, said in an email that the publisher has been aware of paper mills manipulating peer review and has in the past removed compromised papers and editors when they have been found.
She added that new AI and manual tools have helped reject submissions before faulty papers were published.
Some publishers who have investigated suspected paper mill activity at their own journals have acknowledged that people presenting themselves as editors, or hijacking the identity of genuine researchers, is a strategy that paper mills use. Some have instituted more strict ID checks for editors as a result.
In another analysis in the PNAS paper, the authors tracked duplicated images—photographs of sections of tissue, microscope images of cells or DNA analyses in gels appear in identical form in multiple papers. Much like fingerprints, such biological photographs are expected to be unique, so identical images from separate experiments have come to be recognized as an indicator of a mistake or potential fraud.
The authors analyzed reports of duplicated images submitted on PubPeer, a forum where researchers post about problematic papers. They found reports of 2,213 papers containing 4,188 instances where two articles shared the same images, a level of replication that suggested that some of the images had been misappropriated.
While publishers have increasingly acknowledged these operations and said they have taken steps to spot fraud, the authors of the new study show that retractions—in which journals pull papers that appear to have flawed or faulty data—aren't keeping pace with the growth of paper mills.
In 2020, 2,905 published articles were retracted, but more than 4,500 suspected paper mill products were logged in their database. Given that the study's estimates of paper mill activity are likely an undercount, Richardson said, “We know that this barely scratches the surface of what's out there.”
Write to Nidhi Subbaraman at nidhi.subbaraman@wsj.com
Get 360° coverage—from daily headlines
to 100 year archives.
Source: HindustanTimes
Related Posts: Ek Tha Tiger becomes only Indian film to be featured at International Spy Museum Filmo Mein Dekha Tha Interview | Srishti Lakhera opens up on how Ek Tha Gaon took shape Arundel Mills Mall shooting reports Kimber Mills update New York woman charged with smuggling individuals from India into U Indian national indicted for smuggling individuals from across Canadian border into U Individuals must sacrifice ego 7 best open-source apps every student should have to boost learning Find Out Which Is A Better Protein Source For Vegetarians
IndiGo warns of demand hit as Iran war drives up flight ticket pricesIndiGo's warnings come even as an escalating Iran war continues to rattle global crude oil markets and complicates flight paths. Published on: Mar 24, 2026 5:13 PM IST By HT Business Desk Share via Copy link IndiGo has warned that
5 hours ago
Losing stubborn belly fat isn’t just about cutting calories, but it’s about choosing the right kind of movement. The fat stored around your abdomen, especially visceral fat, is closely linked to metabolism and overall health. The good news is that you don’t need hours in the gym
5 hours ago
And so the long goodbye begins for the 'Egyptian King' - undoubtedly, one of the greatest footballers the Premier League has ever seen. Mohamed Salah has worn the Liverpool shirt 435 times across all competitions. At most, he will get the opportunity up to 15 more times between now and the end of
5 hours ago
At his factory in Visakhapatnam, Sanjeev Relhan produces surgical gowns and protective gear that doctors and nurses routinely use in hospitals while handling an infectious patient or for a surgery. Usually, Relhan sells gowns to hospitals for Rs 80 a piece. In the last few days
5 hours ago
Kerala Police asks X to remove posts related to ECI document with BJP sealKerala Police on Tuesday issued notices to social media users and asked platform X to remove posts related to an Election Commission of India (ECI) document that carried the seal of the BJP Published on: Mar 25
5 hours ago
JICA is eager to partner with India on semiconductor and new energy initiatives. The agency plans to invest JPY 275 billion this year, a significant increase from last year's JPY 191 billion. JICA's chief representative, Takeuchi Takuro, highlighted semiconductor manufacturing and biogas as key
5 hours ago
One minute, he’s catching heat for a quiet cameo in the Madrid derby. And the next, he’s at the centre of a bizarre controversy that’s got France and Spain pointing fingers — and Real Madrid sweating. Mbappe’s substitute appearance against Atletico Madrid didn’t exactly wow anyone
5 hours ago
Premier League’s edge blunted as La Liga continues to dictate tempo and control in Champions League Updated on: Mar 25, 2026 6:08 AM IST By Aditya Maheshwari Share via Copy link Premier League may be the most competitive, but La Liga’s technical edge outclasses it in the UEFA Champions League
5 hours ago
Once operational, will Jewar International Airport in Noida, likely to be inaugurated on March 28, be India’s largest airport? There is understandable confusion around this claim. But the short answer is — not yet. But it could be India’s largest airport in the future
5 hours ago
If you cancel between 24 hours and 8 hours before the journey, 50% of your ticket fare will be cut, along with the minimum applicable charge. The Indian Railways has made some major changes to its ticket cancellation fee. From now on, if you cancel your ticket between 24 to 72 hours before the
5 hours ago
Globally, tuberculosis remains the leading cause of death and according to the World Health Organization, over 10.7 million people fell ill with TB in 2024, with more than 1.25 million deaths recorded globally. Despite decades of medical advances
5 hours ago
A tarot reader predicts financial growth for these 5 zodiac signs before March 2026 ends. Here’s whyMarch 2026 Horoscope: According to a tarot reader, Manisha Koushik, a few zodiac signs may experience financial progress before the month ends. Published on: Mar 25
5 hours ago
From April 1, 2026, filing your income tax return (ITR) is set to undergo a significant transformation. With the new Income-tax Rules, 2026 coming into effect, the government is not just tweaking forms—it is reshaping how income, tax and deductions are reported across the system.From April 1
5 hours ago
The Ministry of Civil Aviation has decided to withdraw the temporary fare caps on domestic airfares starting today (March 23). New Delhi: The Ministry of Civil Aviation has decided to withdraw the temporary fare caps on domestic airfares starting today (March 23)
5 hours ago
22-year-old UK woman lands job in Bengaluru, asks if relocating to India is safeThe woman shared that she is also worried about feeling lonely in a new country if she decides to move from the UK to India. Published on: Mar 25, 2026 6:10 AM IST By Trisha Sengupta Share via Copy link A 22-year-old
5 hours ago
The Lok Sabha on Tuesday passed by voice vote the 2026 Transgender Persons Protection of Rights Amendment Bill. The bill will now be moved to the Rajya Sabha. If cleared by the Upper House of Parliament, it will be sent for presidential assent. Introduced in the Lok Sabha on March 13
5 hours ago
Opposition parties are carefully responding to a government proposal to speed up the Women's Reservation Act. They are not opposing it directly but are requesting an all-party meeting. This meeting is proposed to take place after the upcoming assembly elections conclude
5 hours ago
Apex court issued broad directions to correct past injustices and to guarantee equal opportunities in the future. In a landmark judgment stregthening gender equality in the armed forces, the Supreme Court on Tuesday ruled that women Short Service Commission (SSC) officers are entitled to Permanent
5 hours ago
HDFC Bank has appointed domestic law firms Wadia Ghandy and Trilegal, along with a leading US-based firm, to review the circumstances surrounding former chairman Atanu Chakraborty’s abrupt resignation, according to a report by The Economic Times (ET), citing people familiar with the matter
5 hours ago
Singer-rapper Badshah has reportedly tied the knot with Punjabi actress and model Isha Rikhi. Recently, Isha’s mother, Poonam, took to her Instagram handle and shared a series of pictures which suggest that the two are now married. In the photos
5 hours ago
Malaika Arora, in a recent interview, mentioned that she is a massive fan of two Thai dishes. She spoke about her love for green Thai curry rice and mango sticky rice and went on to share how she makes these dishes at home. Green Thai curry or Gaeng Khiao Wan is a fragrant coconut milk-based dish
5 hours ago
Delays in visa appointment scheduling are affecting not only H-1B visa holders but also H-4 dependents, L-1/L-2 employees, and F-1 students. After arriving in India in December, holders with H-1B visas are now ‘stranded in their home country’
5 hours ago
Thousands of Malayalees return home from the UAE, Saudi Arabia, Kuwait and other Gulf states during election seasons to exercise their franchise. Expatriate groups even arrange chartered flights for their members to travel. This year this crowd would have been bigger
5 hours ago
Nandini, the dairy brand of Karnataka Milk Federation, will be the Official Dairy Partner for Royal Challengers Bengaluru in the 2026 IPL season. This partnership unites two prominent Karnataka-based brands. The collaboration aims to connect with passionate RCB fans
5 hours ago
On March 19, Ras Laffan, the largest liquified natural gas terminal in the world, supplying one-fifth of the world’s super-chilled fuel, was hit by Iranian missiles and drones. The Qatari terminal suffered substantial damage in the strikes – fires were raging across the gas-to-liquids facility
5 hours ago
Four European teams will secure their 2026 World Cup spots this week. Sixteen nations are vying for these final four places. Italy faces Northern Ireland in Path A. Ukraine meets Sweden in Path B. Kosovo plays Slovakia in Path C. The Republic of Ireland takes on the Czech Republic in Path D
5 hours ago
Honda’s homecoming at the Japanese Grand Prix was supposed to be a celebration. Instead, it’s shaping up to be an ugly yet much-needed reality check. To state that the new regulations haven’t been kind to Honda — and Aston Martin, in turn — would be an understatement
5 hours ago